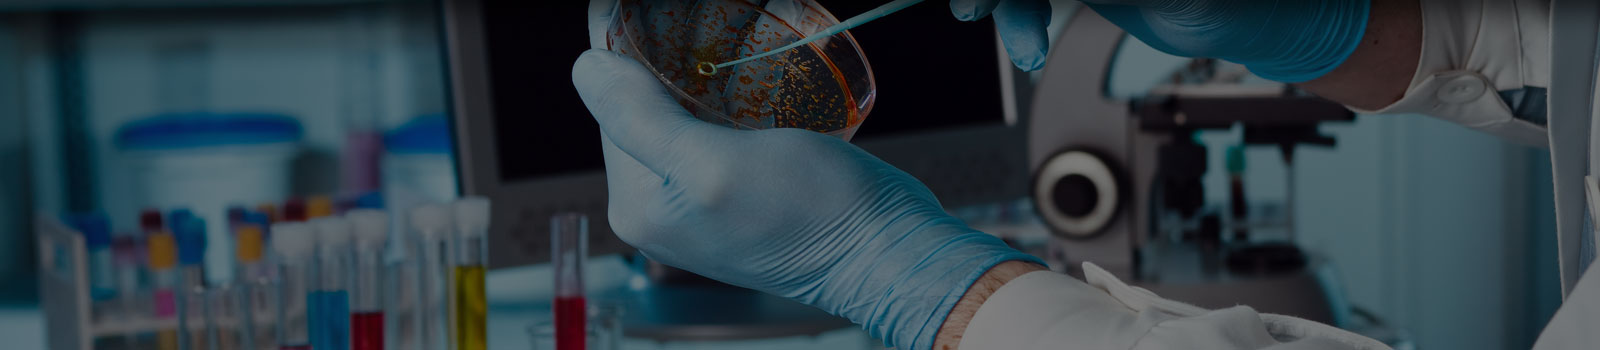

What We Do
Telos Clinical Research’s team of experts can support all aspects of your early development drug and device trials or just fill in the gaps where needed:
- Investigational New Drug Applications (IND) / Chemistry, Manufacturing, and Control (CMC) / Toxicology / Pharmacology / Regulatory writing
- Regulatory strategy and FDA representation
- Registered US FDA agent
- Protocol design, development, and writing
- Vendor selection and management
- Pharmacokinetics design and analysis
- Site identification and feasibility analysis
- Site start-up services (IRB/EC, contract & budget negotiations)
- Project management
- Clinical monitoring
- Safety reporting
- Medical monitoring
- Data management
- Clinical data review and cleaning
- Biostatistics
- Clinical Study Report (CSR) writing
- Data Monitoring Committee (DMC) support